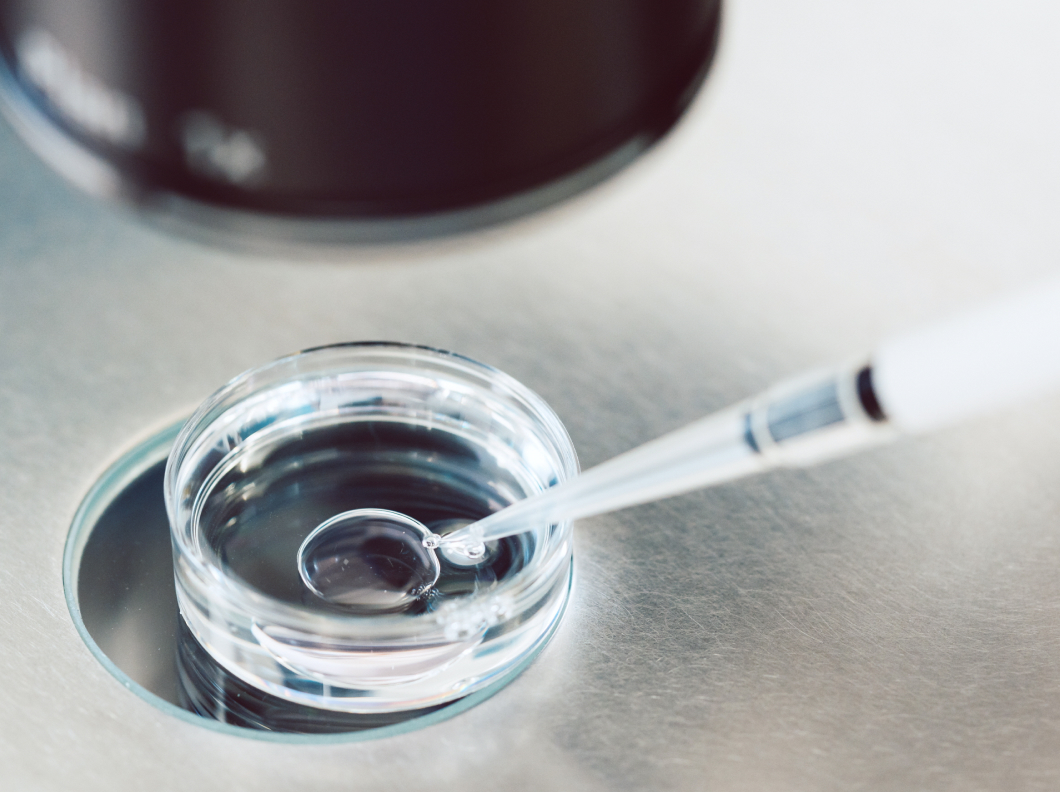

25년 이상 경력의
배아 전문가
이소영연구소장
- 2001~2008 서울 마리아병원 선임연구원
- 2008~2019 송파 마리아병원 책임연구원
- 2019~2024 상봉 마리아병원 연구소장
- 대한생식의학회 회원
- 대한배아전문가협의회 회원
- 대한배아전문가협의회 임상배아 수석 연구원
배양 기술

-
Oocyte Activation
난자 활성화
칼슘 이온 운반체를 통해 난자 내 칼슘 농도를 조절함으로써 수정률을
높이는 방법입니다.

-
Sperm Activation
정자 활성화
정액 내 불순물을 제거하고 정자의 운동성을 향상시키는 특수 처리
과정입니다.

-
TESE: Testicular Sperm Extraction
고환조직 정자 추출
무정자증의 경우 고환 조직 내의 정세관에서 직접 정자를 채취하여
체외수정에 활용하는 시술입니다.
-
IVM: In Vitro Maturation
미성숙 난자 배양 IVM
미성숙 난자가 채취된 경우, 이를 체외에서 성숙 난자로 유도하여
배양시킬 수 있습니다.

-
ICSI: Intracytoplasmic Sperm Injection
세포질 내 정자 주입술
난자의 세포질 안에 정자를 직접 주입해 수정시키는 방법으로, 남성
난임이나 면역학적 요인으로 인해 수정이 반복적으로 실패하는 경우
진행합니다.

-
PICSI: Physiological Intracytoplasmic Sperm Injection
성숙정자 선별 세포질 내 정자 주입술
히알루론산이 코팅된 특수 배지를 이용해 난자와 결합할 수 있는 성숙한
정자를 선별해 수정을 시도하는 방법입니다.

-
IMSI: Intracytoplasmic Morphologically selected Sperm Injection
정자 형태 선별 정자 주입술
고배율 현미경을 이용해 형태가 정상적인 정자만 선별하여 난자에
주입하는 기술입니다.

-
SVICSI: Spindle View Intracytoplasmic Sperm Injection
방추사 관찰 미세조직 시술법
난자의 핵심 구조인 방추사를 특수 편광 현미경을 이용해 실시간으로
관찰한 후, 그 위치를 피해 정자를 주입함으로써 방추사의 손상을
최소화하는 미세수정 기술입니다.

-
Embryo Glue
배아글루
히알루론산이 고농도로 함유된 배양액으로, 배아 이식 시 자궁내막에
배아의 부착력을 높이고 착상률 향상에 도움을 줄 수 있습니다.

-
Laser Assisted Hatching
레이저 보조 부화술
배아가 자궁내막에 착상되기 위해 필요한 투명대 탈출 과정을
인위적으로 도와주는 기술입니다.

-
Micro-Vibration Culture
미세 진동 배양법
미세한 진동 환경을 모사하여 배아의 활성을 촉진하고 발달을 돕는 배양
방법입니다.

-
Vitrification
유리화 냉동
현재 전세계적으로 널리 사용되는 고속 냉동기술로 난자와 배아의
생존율을 높여줍니다.

-
PGT: Preimplantation Genetic Test
착상 전 유전검사
배아의 염색체 수와 구조를 분석하여 정상 염색체를 가진 배아만
선별하여 이식하는 기술입니다.
장비 및 시설

-
Time-lapse Monitoring System Embryoscope©
실시간 배아관찰경
배아의 발달 과정을 실시간으로 모니터링할 수 있는 첨단 배양
시스템으로, 외부 환경에 대한 노출을 최소화하고 착상 가능성이 높은
배아를 보다 정확하게 선별할 수 있습니다.

-
IVF Chamber
체외수정용 작업대
배아와 난자를 다루는 과정에서 외부 온도나 대기 환경으로 인한 영향을
최소화하기 위해 설계된 장비입니다.

-
Clean Room
에어샤워 및 헤파필터, 양압시스템이 설치된
배양실과 시술실공기 중 미세입자와 오염원을 제거하여 배아 생성 및 배양
과정에서 무균에 가까운 청정 환경을 유지하고 있습니다.

-
Frozen Embryo Storage Room
냉동배아 보관실
온도 유지 알람 센서와 잠금장치가 장착된 전용 보관 시설을 통해
생식세포와 배아의 장기 보존에 있어 최적의 안정성과 보안성을
제공합니다.

-
Uninterruptible Power Supply
무정전 전원 공급장치 UPS
정전 등 비상 상황 발생 시 자동으로 내장 배터리로 전환되어 필수
장비에 지속적인 전력 공급이 가능합니다.